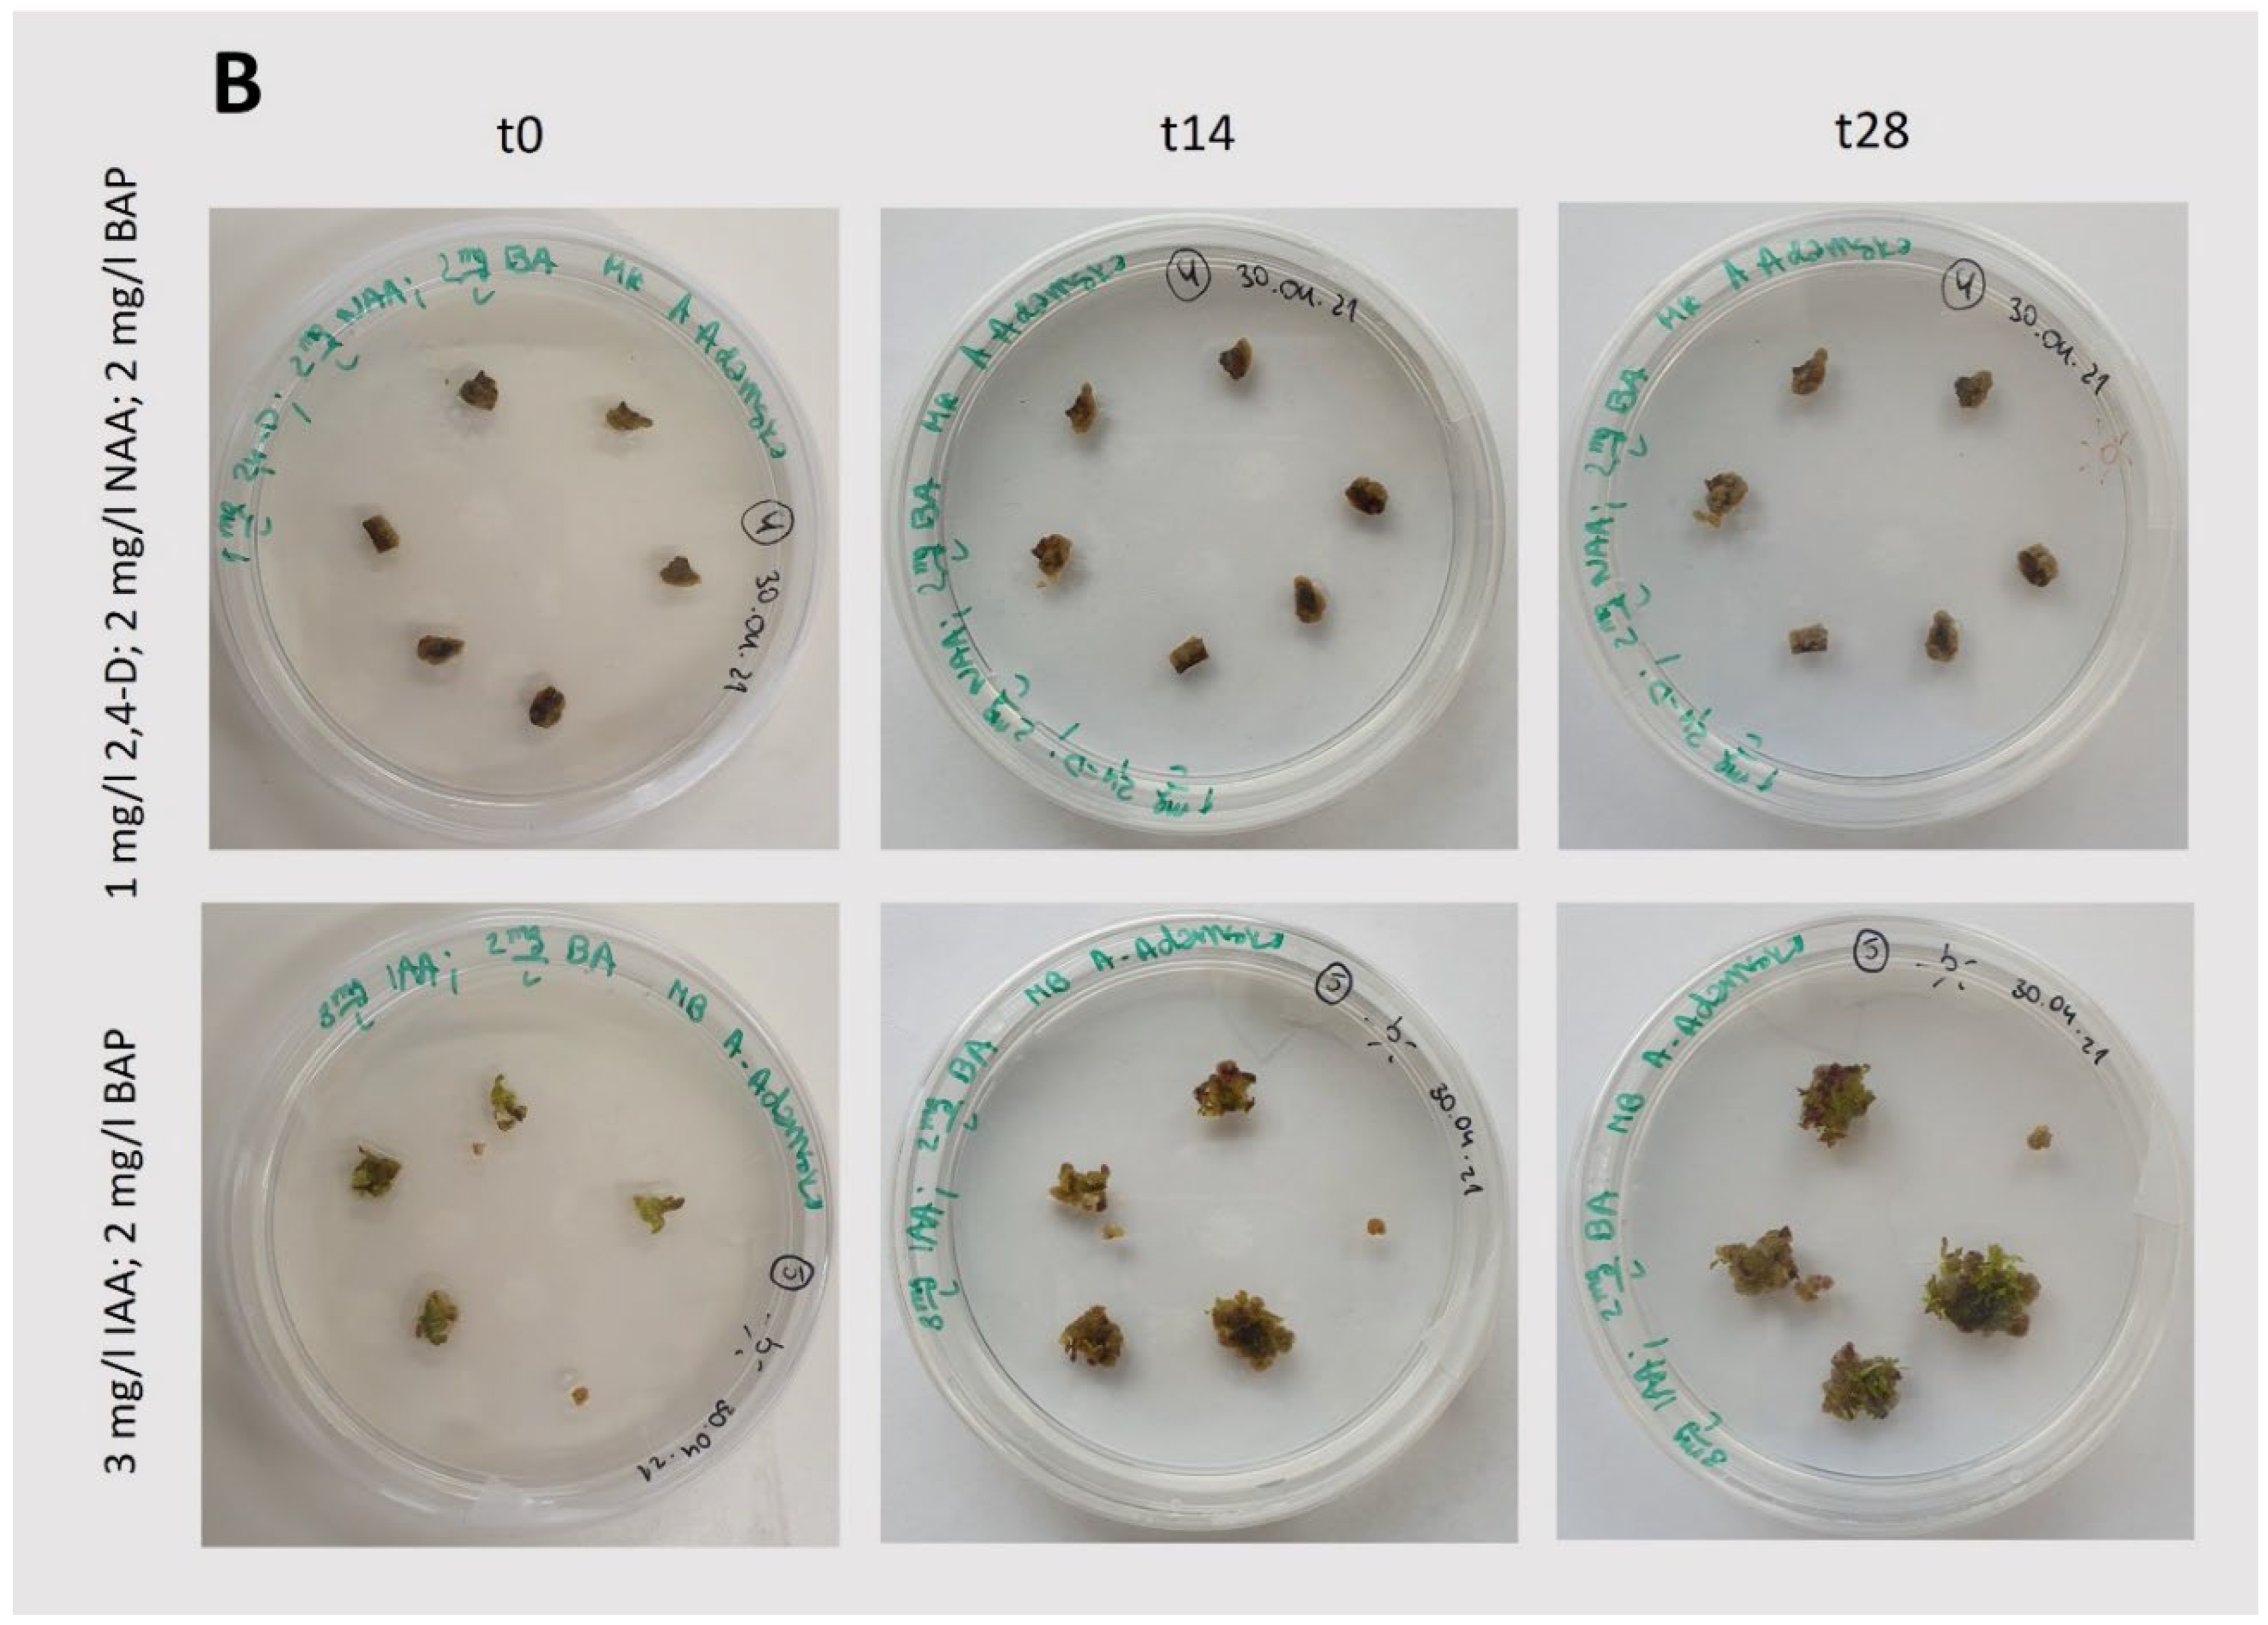
Preprints 119051 g003

1. Introduction
Tussilago farfara L. (coltsfoot) is a perennial species of plant from the
Asteraceae family, a representative of the monotypic genus
Tussilago, which grows primarily in the temperate biome. Its native range includes Europe, a large part of Asia (excluding its southern and eastern ends), and northern Africa. It is currently distributed in up to 46 countries around the world. As an introduced species, it has spread, among others, to North America, India, and the Far East (
https://powo.science.kew.org/taxon/urn:lsid:ipni.org:names:256904-1). In Poland,
T. farfara is a common species, typically found on clay soils. It prefers stony places, scree, riverside gravel pits, landslides, roadside slopes, precipitous banks of rivers and streams, coal dumps and burnt areas. However, it should not be collected in areas where the soil is polluted by industrial waste [
1]. In agricultural crops,
T. farfara is considered a weed. In the classification of plant communities, this species is characteristic of the association
Senecioni-Tussilaginetum [
2]. In introduced areas, coltsfoot can quickly form dense stands that aggressively invade well-established farmland, and some consider it a naturalized causal weed in America [
3]. In agricultural crops,
Tussilago farfara is considered a weed. In the classification of plant communities, this species is characteristic of the association
Senecioni-Tussilaginetum (Matuszkiewicz, 2006). In introduced areas, coltsfoot can quickly form dense stands that aggressively invade well-established farmland, and it is considered a naturalized weed in parts of North America (Chen et al., 2021).
Figure 1.
Exemplary photos of Tussilago farfara L. in its natural habitat. A: Yellow inflorescences (capitula) visible in early spring, developing before the leaves, alongside thin, branched rhizomes. B: Large, round, heart-shaped leaves with radial veins and crinkly, slightly toothed edges, documented in summer.
Figure 1.
Exemplary photos of Tussilago farfara L. in its natural habitat. A: Yellow inflorescences (capitula) visible in early spring, developing before the leaves, alongside thin, branched rhizomes. B: Large, round, heart-shaped leaves with radial veins and crinkly, slightly toothed edges, documented in summer.
Coltsfoot is a herbaceous plant that has long been used in folk medicine. The traditional use of coltsfoot is mainly associated with respiratory health. It has been used to relieve some disorders of this system, such as cough, bronchitis and asthma. Its potential anti-inflammatory properties seem also interesting. In folk medicine, coltsfoot was commonly prepared as an infusion or decoction of dried leaves or flowers in water. Today, coltsfoot continues to attract attention from researchers investigating the potential healing properties of medicinal plant extracts. It is already known that leaves and buds of this species are rich in chemicals, including sesquiterpenes, phenolic acids, flavonoids, alkaloids and others (Chen et al., 2021, Adamczak et al., 2013, Bota et al., 2022). Further research is required to know coltsfoot secondary metabolites and to develop protocols for the extraction and purification of interesting compounds. Additionally, more studied are needed to elucidate the specific mechanisms of action and to determine the safety and effectiveness of coltsfoot in medical applications.
Callus culture plays a key role in plant research. It serves as a model system for studying cellular processes, genetic variability, and the effects of various plant growth regulators and stress conditions on plant cells. A major advantage of this model is the controlled environment, which allows observation of cellular processes without the influence of external factors. Callus culture is also crucial for the conservation of endangered plant species, particularly those endangered today, due to rapidly changing climatic conditions [
6]. Additionally, it aids in the development of genetically modified plants to improve agricultural performance, and in modifying secondary metabolism to produce desired metabolites. Currently, biotechnology is a field in which callus cultures are successfully utilized for producing various primary and secondary metabolites, and scaling up the production of bioactive compounds for pharmaceutical, cosmetic, food applications and phytoremediation) [
7].
According to the definition, a callus is a mass of unorganized, diverse parenchymatous cells, among which there may be totipotent cells capable of regenerating the entire plant organism by organogenesis and/or somatic embryogenesis (Ikeuchi et al., 2013).This ability facilitates the amplification of limited plant material and provides tools for genetic cell transformation, which are not only much more rapid than conventional breeding but also give rise to novel genes and genotypes [
9]. It is commonly known that calli cultures are unstable and characterized by high genetic variability. This feature can be a disadvantage but can be converted into an advantage when such genetically modified callus cultures can be a source of novel bioactive secondary metabolites [
10] and can lead to the generation of plants with improved resistance to salt, drought, diseases, and pests [
6].
Considering all the advantages and wide applications of callus cultures, as well as the specificity of the species with a focus on its medicinal properties and the lack of data in the literature, the development of new protocols and a thorough analysis of cultures still seems necessary. The aim of our research was to develop a protocol for inducing callus from Tussilago farfara L. leaves and to establish callus cultures. We also provided a detailed description of callus growth kinetics, morphological analysis, photosynthetic activity, and biochemical parameters (including protein content and photosynthetic pigments), as well as histological analysis. Moreover, we observed the occurrence of organogenesis and somatic embryogenesis. It should be emphasized that the studies were conducted on plant material already maintained in in vitro culture, which provides a basis for confirming the wide possibility of obtaining material even from the secondary in vitro cultures.
2. Results and Discussion
The experiment encompassed the induction of callus on leaf explants taken from a
T. farfara plant that had already been regenerated from callus. The newly induced callus was then grown under various conditions to determine the optimal growth conditions for callus development. Detailed biochemical and histological characteristics of the callus, along with an analysis of its photosynthetic activity, were performed at various stages of the experiment. The overall experimental scheme is shown in
Figure 2, which serves as a reference for describing the individual experimental steps and analyzes detailed in the following subsections.
2.1. Callus Induction
For callus induction, leaf blades were taken from a
T. farfara plant that had already been regenerated from callus and cultivated in vitro (
Figure 2A). The induction process was performed using different concentrations and types of hormones [
11,
12] under light and dark conditions (
Figure 2B). The results of the tested conditions that ensured callus induction are summarized in
Table 1, and representative photographs are shown in Figs. 3 and 4.

In light-grown cultures, successful induction and growth of callus were observed for each set of phytohormones tested (
Figure 3;
Table 1). However, the growth of this tissue immediately after initiation and after the first passage, still together with leaf fragments (
Figure 2B), was quite limited. Furthermore, the use of indoleacetic acid (IAA; 3 mg/L) with BAP (2 mg/L) under light conditions resulted in intensive organogenesis (
Figure 3B), suggesting that these conditions are not suitable for the cultivation of
Tussilago callus. Similar to light-grown cultures, initiation and growth of callus under dark conditions were observed in the presence of the tested phytohormones (
Figure 4;
Table 1). The largest amounts of callus were obtained with the combination of IAA (3 mg/L) and BAP (2 mg/L). A combination of IAA (2 mg/L) and BAP (2 mg/L) also efficiently induced callus formation, although it was slightly less effective than the higher concentration of IAA.
Based on the analysis of callus growth after initiation and subsequent passages performed in the presence of various hormones, with or without light, the combination of IAA (3 mg/L) and BAP (2 mg/L) appeared to be the most effective condition for
T. farfara callus growth. Similar results were observed in a study of the effects of various auxins and kinetins on callus induction on
Arachis hypogaea cotyledons (Palanivel et. al., 2002), where the most effective set of hormones inducing initiation and the highest increase in callus mass was IAA (3 mg/L) with a slightly lower concentration of BAP (1 mg/L) than in our study. However, the hormone combination that was previously identified as optimal for
T. farfara callus induction (MS with 2,4-D; 2 mg/L and BAP; 3 mg/L) (Ren et al., 2017) induced callus very poorly in our experiments and only under dark conditions (
Table 1).
2.2. Callus Growth Kinetics
Callus growth kinetics were examined for cultures grown in the dark with the selected hormone combination (3 mg/L IAA and 2 mg/L BAP), i.e., under conditions where the callus grew most efficiently (
Figure 2C). We compared callus growth in both solid and suspension cultures (
Figure 2D1 and 2D2). Growth kinetics were analyzed by measuring the increase in fresh weight and parameters such as the Growth Index (GI;[
13]) and Relative Growth Rate (RGR; (Wang et al., 2021, Hunt 2021). The results (fresh weight and GI) indicate intense callus growth on solid medium throughout the entire culture period under these conditions (
Figure 5A). Moreover, the RGR parameter was almost constant, suggesting that the average weight increase per day remained steady. Additionally, the obtained values of the calculated RGR are similar to the rate for callus cultures of other species and confirm the growth phase of the
T. farfara callus culture (Hunt, 2017; Wang et al., 2021). The callus tissue was slightly darker yellow, similar in color to the initial tissue. These findings confirm that the culture parameters were appropriately selected, allowing for the production of a large quantity of vigorous callus material.
In contrast, callus grown in liquid medium showed only a slight increase in tissue fresh weight. After 42 days of observation, the callus had turn brown and was significantly darker than the initial (passaged) tissue lumps at the beginning of the experiment. Furthermore, a comparison of tissue growth parameters on the 42nd day of both cultures (solid and suspension) revealed that tissue growth in liquid medium was minimal compared to the substantial growth observed on solid media (
Figure 5B). Suspension cultures of pharmaceutically important plant cells are quite popular because they enable, for example, the controlled production and extraction of various secondary metabolites of pharmaceutical value in the culture medium. Although suspension culture of callus cells has been used in many plant species [
16], it turned out to be ineffective for
T. farfara in our study. These results suggest that the liquid medium, under our experimental conditions, was unfavorable for
T. farfara callus growth.
To gain more insight into the differences between solid and liquid medium cultures, we performed a series of biochemical tests after 42 days of cultivation, i.e., corresponding to the end of the liquid culture (
Figure 2 D1 and
Figure 2 D2). We focused on measuring protein and pigment content, as well as maximum quantum yield of PSII (F
V/F
M). The amounts of protein, anthocyanins, and carotenoids in callus tissue are shown
Figure 6A. Proteins were found in tissues grown on both media. In solid cultures, their amount was comparable to that measured in intensively growing callus obtained from other plant species [
17,
18,
19]. In contrast, in suspension culture, protein concentration was over 50% lower than in cultures on solid medium, when calculated on a fresh weight basis. The obtained result of biochemical analysis confirm that solid cultures are more favorable than suspension cultures for
T. farfara callus.
Trace amounts of anthocyanins were found in the analyzed callus (
Figure 6A), even though the tissues were cultured in the dark. It has been shown that anthocyanin accumulation in callus is typically stimulated by light (Simões et al., 2009). Small amounts of photosynthetic pigments, such as carotenoids and chlorophylls, were also found in callus from both solid and suspension cultures. Notably, the highest concentration was measured for carotenoids in solid cultures, at approximately 3.5 µg/mg of tissue, followed by Chl b at about half that amount, and the lowest concentration was found for Chl a. This explains the yellowish color of the callus observed in solid cultures. Interestingly, in both types of culture, comparable amounts of Chl a and Chl b were detected, with a slight excess of Chl b. Despite the presence of these trace amounts of photosynthetic pigments, no photosynthetic activity was observed, as the F
V/F
M values remained below 0.1 (
Figure 6A and B). Similar to the protein content, more pigments were found in tissues cultured on solid media. Biochemical tests confirmed that solid medium under the conditions used in this study is better suited for cultivating
Tusilago callus. Therefore, the suspension cultures were not continued or further analysed.
Since we were unable to find reference data on the relative amounts of photosynthetic pigments in
T. farfara leaves, we measured the pigment content in leaves of this plant grown in vitro (
Figure 2A) to explain the unusually high relative Chl b content in the analyzed callus (
Figure 6B). For comparison, we also examined the pigment content in callus grown under light conditions, using identical light conditions for both the plant and the callus. The results are presented in
Table 2.
Significant amounts of Chl a, Chl b, and carotenoids were found in the leaf tissues (
Table 2). Notably, the Chl a/Chl b as well as Chls/carotenoids ratios were within the range observed in higher plants [
21,
22]. Leaf tissue contained, on average, about 32 and 21 times more Chl a and Chl b, respectively, and 14 times more carotenoids than light-grown callus (
Table 2). These differences may result, among other factors, from the type of tissue used for measurement. In the case of callus, it was yellow-brown tissue with green regenerates, whereas the leaf blades collected for the study were completely green. Moreover, the relative pigment proportions were different. In callus, there were relatively more carotenoids and Chl b than in leaf tissues. Nevertheless, the observed predominance of Chl b over Chl a in dark-grown callus (
Figure 6B;
Table 2) was rather an exception. It is likely the result of Chl biosynthesis induced during the passage procedure, which was not performed in darkness, combined with Chl catabolism during the callus growth in the dark. Carotenoids synthesis can proceed in the absence of light [
23].
2.3. Organogenesis
Under the cultivation conditions of
T. farfara in solid cultures that we studied, organogenesis was frequently observed. As shown by the results of callus induction (Figs. 3 and 4), the growth and efficiency of organogenesis depended on culture conditions, such as the presence or absence of light and the supplementation of appropriate hormones. Therefore, we examined the influence of light and darkness on the intensity of organogenesis using the medium identified as optimal for the intensive growth of
T. farfara callus in darkness (i.e., MS with 3 mg/L IAA and 2 mg/L BAP). For comparison, we also used the medium for the regeneration of
T. farfara plants (i.e., MS), which was the source of leaf explants in our study (
Figure 2A). The obtained results indicate that in the used in vitro conditions in the process of
T. farfara organogenesis, light played an important and beneficial role, a similar effect of light was observed in cultures of
Lilium usitatissimum L., in which light clearly promoted organogenesis and its cyanogenic potential [
24] as well as in cucumber cultures [
25]. In addition to comparing callus color, we quantitatively analyzed the number and types of organs produced by callus in these 42-day-old cultures (
Figure 2E). The results are shown in
Table 3 and
Figure 8. Significant differences in callus morphology were observed, as well as variations in the number and color of regenerates depending on the culture conditions. Pieces of callus were usually inhomogeneous in color, with tints of various colors easily observable (
Figure 8) and quantified in
Table 3. The observed violet tints indicated the accumulation of anthocyanins [
20].
Callus grown in the dark on the selected optimum medium (i.e., MS with IAA and BAP,
Table 1) was yellow or slightly brown with a small amount of anthocyanins (
Figure 8;
Table 3). In contrast, callus grown on a medium dedicated to plant regeneration (MS only) was noticeably darker. Callus grown under light conditions appeared completely different; it was light brown or slightly dark brown with a large amount of anthocyanins, especially when grown on medium with IAA and BAP. In this case, a larger amounts of regenerates were also observed. While most regenerates on callus grown in the dark were characterized as roots, in light conditions, most were leaves, especially on medium with MS only (
Table 3,
Figure 8). An interesting correlation with exposure to growth regulators is shown by regenerants that retain greenish in the absence of plant growth regulators in the medium and are deprived of green color (they are colorless) when exposed to the presence of IAA and BAP. A reduction in the number of albino spring barley microspores was obtained by replacing BAP with another cytokinin TDZ (thidiazuron) [
26]. It is possible that such an effect could also be obtained in
T. farfara cultures using this amine cytokinin, which may not terminate/interrupt the deetiolation process but delays it, as indicated by the data obtained from the measurement of photosynthetic pigment activity. Symons and Reid [
27] discuss the interactions between light and plant hormones and their role in mediating phenotypic change during de-etiolation. Recent molecular data provide evidence of interactions between light-and IAA/CK-signaling pathways and it is possible that in this aspect the explanation of the discussed issue should be sought in the future.
2.4. Histological Callus Analysis
Histological analysis of 42-day-old callus samples grown on solid media (MS or MS with 3 mg/L
IAA, 2mg/L BAP and 0,6% agar) selected for the highest morphogenetic potential, from dark and light conditions 75 μmol photons m
-2 s
-1) (
Figure 2E), confirmed previous macroscopic observations. Although the histological analysis proved mostly the organogenesis appearance (
Figure 9. B1, C1, D1) in each culture type, the symptoms of somatic embryogenesis could not be excluded, because they were noticeable in the form resembling proembryogenic structures, characteristic only for the light conditions. Similar structures were present in in vitro cultures of another member of the
Asteraceae,
Taraxacum belorussicum, analogously stopped early in their development and did not develop into distinct somatic embryos [
28]. The presence and distribution of the extracellular matrix (ECM) also appear to be light-dependent, the bigger quantity of it was noticeable for the callus maintained in light than in the darkness and was mostly located on the edge of the callus (
Figure 9 A2, D2a). Recent research shows that the ECM composed of proteins and polysaccharides, has a big influence on the functioning of the cells, ensuring, among other things, effective cellular communication and protection [
29]. Furthermore, it was shown that the ECM implies an active role in plant morphogenesis. [
29,
30,
31] In the light conditions starch was stored in the plastids which were often located around the nucleus. The lack of light had a negative impact on the presence of starch in callus cells, it was found there sporadically. A common and characteristic feature of the callus from each experimental system was its high cytological diversity with callus. The callus clusters consisted of cells of large size, irregular shape, and highly vacuolated along with the small isodiametric cells with low vacuolization degree, dense cytoplasm, and well-visible multi-nucleoli nuclei resembling the cells of meristematic character. Such the cells were present both among the callus clumps and in the body of regenerants.(
Figure 9). In the tested callus derived from each condition, cell differentiation toward the vascular tissue was not observed. Neither xylem nor phloem elements were present in analyzed samples, except in a few cases from light and dark conditions and PGRs supplementation, where slight traces of individual/single protoxylem vessels were noticeable. It seems surprising that long-term, stabilized callus lacks neovascularization, which ensures optimal transport of nutrients and is common in many other callus cultures [
28,
32,
33]. However, the phenomenon of
T. farfara is not an isolated one, as the stabilized non-morphogenic callus of kiwi (
Actinida arguta) also completely lacks elements of vascular tissues what was related with the specific level of auxins and cytokinins [
32]. When looking for the causes of this phenomenon, one should take into account the supplementation of sugar and auxins, which, as confirmed by literature data, are necessary for the neovascularization of callus [
34,
35,
36]. These factors were ensured in the studied coltsfoot callus cultures, so the reasons for the lack of induction of a sophisticated vascular network consisting of water-conducting vessels and assimilate-transporting sieve elements, should be, probably looked for in the species specificity and the selection of appropriate auxins.
In the histological images of all experimental systems of the studied
T. farfara callus, the presence of multinucleated cells (
Figure 9 A2) and the presence of several nucleoli in large nuclei were clearly common (
Figure 9 B2) as well as the unfinished cytokinesis appearance (
Figure 9 A2). Following Häsler’s observations [
37] this phenomenon can be attributed to the characteristics of cell cancer. The authors observed the loss of totipotency of callus cells, which then have started to acquire some features (polynucleolation, nuclear invaginations, incomplete cell wall etc.) that are typical of the neoplastic cells. Images of mitotic divisions are in fact very rare, which may suggest that the increase in calli biomass relies more on these types of atypical partial or complete cell divisions than on simple mitosis [
37]. The observation revealed that mitotic activity even weak, was correlated with the callose distribution. Callose was deposited in different places and this varied localization was related to the conditions of callus culture. In the dark-grown callus without PGRs, callose was present in the cell plate visible probably during cytokinesis (
Figure 9 A3) and in much smaller amounts than in callus originating from light and darkness on medium supplemented with PGRs (
Figure 9 B3, C3, D3). Light conditions and exposure to IAA and BAP resulted in two modes of callose deposition. In the walls of strongly vacuolated large parenchymal cells, a thin polysaccharide deposit was observed, while in the walls of smaller cells, also of a parenchymal nature, callose deposits took the form of extremely thick plugs (
Figure 9B3, C3, D3), so thick that they refracted light in the microscope. Taking into account the multiple functions of callose and the fact that the examined callus cultures lack phloem elements, the presence of callose in this material translates, among other things, into mediating the separation of daughter cell nuclei as a transient component of the middle lamina during cytokinesis. Moreover, the controlled deposition of callose in plasmodesmata regulates simplistic transport in the callus, and the thick deposits of this polysaccharide can be explained by an enhanced response to abiotic stress. Under natural conditions, such a thickened structure called a papilla prevents the entry of pathogens during infection [
38].
2.5. Photosynthetic Activity of Callus with Regenerants
Finally, we studied the ability of the regenerants to grow under different light intensity, lower and higher than used for callus cultivation. The dark-grown callus, exhibiting clear symptoms of initial organogenesis (
Figure 2E), was transferred to white light with a photon flux density of 70 μmol m
-2 s
-1 for 6 days. Then it was subcultured and cultivated under different white light intensities: 30, 70 and 90 μmol photons m
-2 s
-1 (
Figure 2F). Photosynthetic activity was assessed using chlorophyll fluorescence imaging before the passage, as well as 3 and 22 days thereafter, following a 10-min preadaptation to darkness (
Figure 10). The average F
V/F
M value was the lowest for callus before the passage, i.e., after 6 days of growth in light. It significantly increased in cultures performed under 30 and 70 μmol photons m
-2 s
-1 already after 3 days of growth on fresh medium. However, this increase was less evident in the case of callus growth under 90 μmol photons m
-2 s
-1 (
Figure 10A). In turn, only in this case was an increase in F
V/F
M observed after 22 days of cultivation, while a decrease in this parameter was noted for cultivations at 30 and 70 μmol photons m
-2 s
-1. Nevertheless, even the highest observed F
V/F
M is much lower than values characteristic for plant, usually around 0.83-0.86 [
39].
No significant differences were observed among callus cultivated under different light intensities with respect to photosynthetic activity (
Figure 10B). The coefficient of photochemical quenching (qP) was very low under the actinic light treatment (below 0.1). This parameter represents the fraction of open photosystem II centers, thus participating in the photosynthetic electron transport chain (Horton et al., 1996)(Horton et al., 1996). The obtained results indicate rapid saturation of this chain. Furthermore, rapid opening of the photosystem II centers was observed after switching off the actinic light, demonstrating their functionality. In line with this observation, the induction of nonphotochemical quenching (NPQ) was observed under actinic light, representing the dissipation of excess absorbed energy [
41]. This means that light harvesting complexes are already assembled, although the maximal NPQ reached by callus is very low as compared to leaves. Additionally, the empirical parameter, vitality index (R
fd), shows typical induction in light and was slightly lower for callus grown under the lowest light intensity. Moreover, this parameter was always smaller than those reported for leaves[
42].
The fluorescence intensity was unevenly distributed on the callus surface (
Figure 10D), despite the fact that in each case, the surface was covered with green regenerates (
Figure 11).
We showed that callus with regenerants developed in dark-grown cultures, can develop photosynthetically active shoots within 6-day -period under light. Moreover, these newly formed shoots exhibits traits of adaptation to different light intensities and can be transferred to higher or lower light intensity without harm. However, the amount of anthocyanins varies with light intensity—the higher the light, the more anthocyanins are produced (callus becomes more intensively violet) [
20].
3. Materials and Methods
3.1. Plant Material for Callus Induction
The plant material used for callus induction in this study was
Tussilago farfara L. (coltsfoot) plant from a sterile culture, which was regenerated from callus (hereafter referred to as ‘primary callus’) in our laboratory via the following procedure. First, a wild-growing
T. farfara specimen [
Figure 1] was collected from meadows near the Campus of the 600th Anniversary of the Jagiellonian University in Kraków (50°01′44,396″N 19°54′17,496″E; Poland).
From this stage onwards, all work was carried out under sterile conditions. Explants (leaves) taken from the
T. farfara L. plant were surface sterilized by immersion in 70% ethanol for 1 min, followed by immersion in 10% commercial bleach (ACE, Procter and Gamble DS Poland) with a few drops of Tween 20 for 20 min. They were then rinsed three times in sterile deionized water. The leaves were cut into slices approximately 15 to 20 mm and placed on 90-mm Petri dishes containing Murashige and Skoog media (MS, Duchefa, Haarlem, The Netherlands) (Murashige and Skoog 1962) supplemented with 3% sucrose (Chempur) and 2 mg/L 4-amino-3,5,6-trichloropicolinic acid (Picloram, Duchefa, Haarlem, The Netherlands) and 2 mg/L
benzyl-aminopurine (BAP; (Duchefa, Haarlem, The Netherlands). The pH of the medium was adjusted to 5.8, and supplemented with 0,6% agar (Roko, Spain) prior to autoclaving (20 min at 121°C) according to Kedra and Bach [
43]. The primary callus induction was carried out in the dark in a test chamber (Versatile Environmental Test Chamber, MLR 351H, Sanyo, Japan) at 23°C. Callus cultures were passaged four times onto fresh medium.
For the regeneration of a plant in vitro, a piece of callus was placed in a 50 mL falcon tube with 15 mL of medium (MS medium, pH 5.8 supplemented with 30 g/L sucrose and solidified with 0,6% agar. The cultures were kept at 20°C under white light illumination (75 μmol photons m-2 s -1) and a 14/10 (light/dark) photoperiod for up to 10 weeks. The cultures of regenerated T. farfara plants were refreshed by transferring explants in the form of stems with 1 or 2 leaves onto fresh medium every 8 weeks. The cultivation conditions remained unchanged.
This culture was maintained for 5 years before being used as the starting material (leaf explants) for callus production described in this study.
3.2. Callus Induction
Callus culture was induced on explants taken from the second and third leaves of 5- to-10-week-old regenerated
T. farfara plants grown in sterile cultures (
Figure 2A). Leaves cut in half crosswise or lengthwise were placed on Petri dishes with MS medium and 30 g/L sucrose, pH 5.8, solidified with 0,6% agar. The medium was supplemented with different plant growth regulators: 2–3 mg/L
indoleacetic acid (IAA), 1–2 mg/L 2,4-dichlorophenoxyacetic acid (2,4-D), 2 mg/L naphthalene acetic acid (NAA), 2–3 mg/L benzyl aminopurine (BAP). The specific hormone compositions are provided in the result section. The cultures were grown at 20°C either under white light illumination (75 μmol photons m
-2 s
-1) with a 14/10 (light/dark) photoperiod or in darkness.
The observation was carried out after 14 and 28 days (Figure 2B).
After the callus induction (i.e., after 28 days), callus tissue was separated from explants as much as possible and were placed on next Petri dishes with the same medium as used for callus induction. The growth of callus was carried out at the same experimental condition as the initiation. Every 4 weeks, for two years the callus was subcultured to the same fresh medium (
Figure 2C).
3.3. Callus Growth
Callus cultures (
Figure 2C) were transferred and subsequently grown in suspension (in 50 mL cell culture bottles;
Figure 2D1) or on solid medium (on Petri dishes;
Figure 2D2). The MS medium (pH 5.8) contained 30 g/L sucrose and growth regulators: 3 mg/L IAA and 2mg/L BAP. For solid cultures, the medium was solidified with 0,6% agar. Both suspension and solid cultures were kept at 20°C in dark.
To study the light effect on callus culture, some Perti dishes were kept under illumination (75 μmol photons m
-2 s
-1) and 14/10 (light/dark) photoperiod, and the rest was continued in the dark (
Figure 2E). Finally, the effect of different light conditions on callus growth and organogenesis was caried out on different light intensity: 30, 75 or 90 μmol photons m
-2 s
-1 (
Figure 2F).
3.4. Callus Growth Kinetics
For the callus growth
kinetics fresh mass of callus clumps were examined (
Figure 2D1 and D2). Changes in callus mass on solid media were checked every 7 days and the culture conditions were not refreshed. For technical reasons, in liquid media, these measurements were taken twice: at the beginning of the experiment before inoculation into the medium and at the end of the experiment on the 42nd day of culture.
The values were taken for calculation of the Growth Index (GI, [
13] and Relative Growth Rate (RGR, [
14]) parameters using the following equations:
RGR = (lnW
t − lnW
0)/(t − t
0) [mg/day] [
2]
where: Wt - the fresh weight of callus at time t
W0 - the initial fresh weight of callus at the beginning of the treatment (t0) or beginning of harvest interval
t - time (day of experiment)
t0 - beginning of experiment or harvest interval
3.4. Biochemical Analysis
Callus (
Figure 2D1, D2 and F). was disintegrated by using grinding rods and beads garnet (quality: 50 pcs) in Eppendorf tube using mini-homogenizer (Tissue mini grinder E0357, EURx, Polska) kept on ice in the present of appropriate medium (depending of biochemical analysis).
3.4.1. Protein analysis was performed in disintegrated tissue in the presence of 1M NaOH and water (1:1). After centrifugation (5 min, 12000 rpm, Eppendorf) protein concentration were measured by Lowry method [44].
3.4.2. Chlorophylls and carotenoids were extracted from disintegrated tissue by 80% acetone. After centrifugation (5 min, 12000 rpm, Eppendorf) concentration of chlorophylls and carotenoids in extract was determined with a spectrophotometer (Jasco 870, USA) and calculated by the Lichtenthaler method [45].
3.4.3. The content of anthocyanin pigments was determined using the differential spectrophotometric method of Giusti and Wrolstad [46]. Anthocyanin pigments from callus was extracted by 80% acidified ethanol solution by 0.1 N hydrochloric acid. The extract was then mixed with a buffer of pH 1 and 4.5 and measured absorbance at a wavelength of 530 and 800 nm (Metertek SP-930 spectrophotometer, Taiwan).
3.5. Observation of Callus Tissue
Calli observation and photographic documentation was made using a stereo microscope (SK Series Microscope, OPTA-TECH, Poland) equipped with an HDMI series camera and OPTAViewIS (ver. 4.3.0.6001) directly on Petri dishes. Based on observations and photographic documentation made using of camera software an analysis of the callus morphology and organogenesis was carried out.
3.6. Histological Callus Analysis
Calli samples (
Figure 2E) from each kind of media (MS or MS with 3 mg/L
IAA, 2mg/L BAP and 0,6% agar) and different conditions (dark or light : 75 μmol photons m
-2 s
-1) after 42 days of culture were fixed in a mixture of 5% glutaraldehyde and phosphate buffer, pH 7.2 (Sigma) in 5 °C overnight. Next the samples were washed four times in 0.1 M phosphate buffer (pH 7.2), dehydrated in an ethanol series (10%, 30%, 50%, 70%, 96%; 15 min each) and kept overnight in absolute ethanol. The fixed calli were subsequently embedded in Technovit 7100 (Heraeus Kulzer, South Bend, Indiana, USA) synthetic resin. Plant material histology block slices (7 μm of thickness) were obtained using a rotational microtome—Microm HM 355 S I Microtome (MICROM International GmbH, Walldorf, Germany).
The sections were stained with 0.1% toluidine blue O, naphthol blue black for proteins detection [
28], periodic acid-Schiff’s (PAS) reagent for water-insoluble polysaccharides identification ((Jensen, 1962), modified by Tuleja et al., [
48]), aniline blue for callose [
49], and mounted in histological medium (Enthellan; Merck Millipore, USA).
Observations and documentation were performed using a Nikon Eclipse E400 light microscope. The sections treated with aniline blue were analyzed under UV light using a Nikon Eclipse E400 microscope with an Epi-FL Filter Block N UV-2A (EX330–380, DM400, BA420). Photographic documentation was made with a digital camera and NIS-Elements D software.
3.7. Chlorophyll In Vivo Fluorescence Measurements
Chlorophyll in vivo fluorescence methods were used for F
V/F
M determination [
50,
51]
. Fv/Fm measurements were performed using a Pocked PEA Chlorophyll Fluorimeter (Hansatech Instruments, UK) according to a standard protocol. Before the measurement, callus fragments (approx. 100 mg), (
Figure 2D1 and D2) were dark-adapted for 15 min.
Chlorophyll fluorescence imaging of callus samples (
Figure 2F) on Petri dishes (MS with 3 mg/L
IAA, 2mg/L BAP and 0,6% agar) and different light conditions (30, 75, 90 μmol photons m
-2 s
-1) was performed using a pulse-modulated Open Fluor-Cam FC 800-O/1010 fluorimeter and analysed using a FluorCam7 software (PSI, Drasov, Czech Republic). The standard ‘F
V/F
M’ and ‘QuenchingAct2’ protocols were used. Samples were pre-incubated in darkness for 10 min immediately before measurement. Image and setting optimization was performed before darkening. The intensity of the saturating pulse was set at 3700 μmol photons m
-2 s
-1 and that of the actinic light was 550-600 μmol photons m
-2 s
-1. The following parameters were calculated from the quenching analysis: NPQ (nonphotochemical quenching), qP (coefficient of photochemical quenching, which estimate of the fraction of open PSII reaction centers), and R
fd (fluorescence decline ratio; an empiric parameter used to assess plant vitality). The average values for 6 repetitions along with respective standard deviations, were calculated.
4. Conclusions
The efficient protocol for the induction, stabilization, and continuous growth of callus from Tussilago farfara L. in vitro regenerants has been established. The viable callus achieved via secondary induction was maintained continuously for two years. It is recommended that Tussilago callus be grown in darkness; light reduces the growth rate. In the dark, the callus maintains a constant growth rate, which may be related to the anergization phenomenon. Under these conditions, higher mitotic activity was observed, as confirmed by histological images showing the callose presence in plate cells. The appearance of ECM (extracellular matrix) and symptoms of somatic embryogenesis, based on histochemical analysis, indicates a high morphogenetic potential of this long-term callus. Light enhances organogenesis.
We have also shown that, under experimental conditions, indirect organogenesis is achievable, even with a growth protocol designed for callus tissue.
Our research is also significant in the context of climate change, when climate warming may adversely affect the development cycle of this early spring species. The potential interference in the natural habitat of T. farfara caused by climate change and the shortening of the spring period may also pose a threat to coltsfoot. Developing in vitro cultivation methods can help safeguard the native gene pool. Establishing a long-term callus culture protocol is an important tool for biotechnological sources of metabolites.
Finally, we demonstrate that regenerated callus has low photosynthetic activity compared to leaves, but this activity is not dependent on light conditions. Additionally, chlorophyll fluorescence induction and relaxation was similar to that of plants, but weaker.
Author Contributions
Conceptualization, MB, MK, MT, BM-K; methodology, MB, MK, MT, BM-K; formal analysis, MB, MT, BM-K; investigation, MB, MK, AA, ZJ, MT, BM-K; resources, MB, MK; data curation, MB, MT, BM-K; writing—original draft preparation, MB, MK, MT; writing—review and editing, BM-K, MB, MT, MK; visualization, MB, MT, BM-K; supervision, BM-K; All authors have read and agreed to the published version of the manuscript.
Funding
This research received no external funding.
Data Availability Statement
The original contributions presented in the study are included in the article, further inquiries can be directed to the corresponding author.
Conflicts of Interest
The authors declare no conflicts of interest.
References
- Tobyn, G.; Denham, A.; Whitelegg, M. ; CHAPTER; coltsfoot; Tobyn, G.; Denham, A.; Whitelegg, M.; Herbs, M.; Livingstone, C.; Edinburgh, 2011: pp. 317–326. [CrossRef]
- Matuszkiewicz, W. Przewodnik do oznaczania zbiorowisk roślinnych Polski. Wydawnictwo Naukowe PWN, 2006.
- Chen, S.; Dong, L.; Quan, H.; Zhou, X.; Ma, J.; Xia, W.; Zhou, H.; Fu, X. A review of the ethnobotanical value, phytochemistry, pharmacology, toxicity and quality control of Tussilago farfara L. (coltsfoot). J Ethnopharmacol 2021, 267, 113478. [Google Scholar] [CrossRef] [PubMed]
- Bota, V.B.; Neamtu, A.A.; Olah, N.K.; Chi, E.; Burtescu, R.F.; Furtuna, F.R.P.; Nicula, A.S.; Neamtu, C.; Maghiar, A.M.; Ivănescu, L.C.; et al. A Comparative Analysis of the Anatomy, Phenolic Profile, and Antioxidant Capacity of Tussilago farfara L. Vegetative Organs. Plants 2022, 11, 1663. [Google Scholar] [CrossRef] [PubMed]
- Adamczak, A.; Opala, B.; Gryszczyńska, A.; Buchwald, W. Content of pyrrolizidine alkaloids in the leaves of coltsfoot (Tussilago farfara L.) in Poland. Acta Soc. Bot. Pol. 2013, 82, 289–293. [Google Scholar] [CrossRef]
- Efferth, T. Biotechnology Applications of Plant Callus Cultures. Engineering 2019, 5, 50–59. [Google Scholar] [CrossRef]
- Acharjee, S.; Kumar, R.; Kumar, N. Role of plant biotechnology in enhancement of alkaloid production from cell culture system of Catharanthus roseus: A medicinal plant with potent anti-tumor properties. Ind. Crops Prod. 2022, 176, 114298. [Google Scholar] [CrossRef]
- Ikeuchi, M.; Sugimoto, K.; Iwase, A. Plant callus: Mechanisms of induction and repression. Plant Cell 2013, 25, 105070. [Google Scholar] [CrossRef] [PubMed]
- Yin, R.; Chen, R.; Xia, K.; Xu, X. A single-cell transcriptome atlas reveals the trajectory of early cell fate transition during callus induction in Arabidopsis. Plant Commun. 2024, 5, 100941. [Google Scholar] [CrossRef]
- Thakur, K.; Partap, M.; Kumar, P.; Sharma, R.; Warghat, A.R. Understandings of bioactive composition, molecular regulation, and biotechnological interventions in the development and usage of specialized metabolites as health-promoting substances in Siraitia grosvenorii (Swingle) C. Jeffrey. J. Food Compos. Anal. 2023, 116, 105070. [Google Scholar] [CrossRef]
- Palanivel, S.; Parvathi, S.; Jayabalan, N. Callus induction and plantlet regeneration from mature cotyledonary segments of groundnut (Arachis hypogaea L.). J. Plant Biol. 2002, 45, 22–27. [Google Scholar] [CrossRef]
- Ren, J.W.; Lei, Y.; Li, X.L. Tissue culture of callus and establishment of regeneration system of Tussilago farfara petiole. Zhongguo Zhong Yao Za Zhi 2017, 42, 3895–3900. [Google Scholar] [CrossRef]
- Shah, M.; George, I.A. Pigment elicitation and sun protection factor of callus induced from Cassia tora seedling explants. Plant Cell Tissue Organ. Cult. 2020, 143, 201. [Google Scholar] [CrossRef]
- Wang, K.T.; Hong, M.C.; Wu, Y.S.; Wu, T.M. Agrobacterium-mediated genetic transformation of taiwanese isolates of lemna aequinoctialis. Plants 2021, 10, 1576. [Google Scholar] [CrossRef] [PubMed]
- Hunt, R.; Analysis, G.; Plants, I.; Thomas, B.; Murray, B.G.; Murphy, D.J. Encyclopedia of Applied Plant Sciences, 2nd ed.; Academic Press: Oxford, 2017; pp. 421–429. [Google Scholar] [CrossRef]
- Gantait, S.; Das, A.; Mitra, M.; Chen, J.T. Secondary metabolites in orchids: Biosynthesis, medicinal uses, and biotechnology. S. Afr. J. Bot. 2021, 139, 338–351. [Google Scholar] [CrossRef]
- da Silva, A.L.C.; Caruso, C.S.; de A, R.; Horta, A.C.G. Growth characteristics and dynamics of protein synthesis in callus cultures from Glycine wightii (Wight & Arn.) Verdc. Ciência E Agrotecnologia 2005, 29, 1166. [Google Scholar] [CrossRef]
- Pajević, S.; Vasić, D.; Sekulić, P. Biochemical Characteristics and Nutrient Content of the Callus of Sunflower Inbred Lines. Helia 2004, 27, 143–150. [Google Scholar] [CrossRef]
- Kumar, N.; Pamidimarri, S.D.V.N.; Kaur, M.; Boricha, G.; Reddy, M.P. Effects of NaCl on growth, ion accumulation, protein, proline contents and antioxidant enzymes activity in callus cultures of Jatropha curcas. Biologia 2008, 63, 378–382. [Google Scholar] [CrossRef]
- Simões, C.; Bizarri, C.H.B.; da Silva Cordeiro, L.; de Castro, T.C.; Coutada, L.C.M.; da Silva, A.J.R.; Albarello, N.; Mansur, E. Anthocyanin production in callus cultures of Cleome rosea: Modulation by culture conditions and characterization of pigments by means of HPLC-DAD/ESIMS. Plant Physiol. Biochem. 2009, 47, 895–903. [Google Scholar] [CrossRef]
- Pashkovskiy, P.P.; Soshinkova, T.N.; Korolkova, D.V.; Kartashov, A.V.; Zlobin, I.E.; Lyubimov, V.Y.; Kreslavski, V.D.; Kuznetsov, V.V. The effect of light quality on the pro-/antioxidant balance, activity of photosystem II, and expression of light-dependent genes in Eutrema salsugineum callus cells. Photosynth. Res. 2018, 136, 199–214. [Google Scholar] [CrossRef]
- Dale, M.P.; Causton, D.R. Use of the Chlorophyll a/b Ratio as a Bioassay for the Light Environment of a Plant. Funct. Ecol. 1992, 6, 190. [Google Scholar] [CrossRef]
- Cazzonelli, C.I.; Pogson, B.J. Source to sink: regulation of carotenoid biosynthesis in plants. Trends Plant Sci. 2010, 15, 266–274. [Google Scholar] [CrossRef]
- Siegień, I.; Adamczuk, A.; Wróblewska, K. Light affects in vitro organogenesis of Linum usitatissimum L. and its cyanogenic potential. Acta Physiol. Plant 2013, 35, 781–789. [Google Scholar] [CrossRef] [PubMed]
- Miguel, J.F. Effect of Light Conditions on In Vitro Adventitious Organogenesis of Cucumber Cultivars. International Journal of Plant, Animal and Environmental Sciences 2022, 12, 138–144. [Google Scholar] [CrossRef]
- Esteves, P.; Clermont, I.; Marchand, S.; Belzile, F. Improving the efficiency of isolated microspore culture in six-row spring barley: II-exploring novel growth regulators to maximize embryogenesis and reduce albinism. Plant Cell Rep. 2014, 33, 871–879. [Google Scholar] [CrossRef] [PubMed]
- Symons, G.M.; Reid, J.B. Interactions between Light and Plant Hormones during De-etiolation. J Plant Growth Regul 2003, 22, 3–14. [Google Scholar] [CrossRef]
- Gałuszka, A.; Gustab, M.; Tuleja, M. In vitro morphogenetic responses from obligatory apomictic Taraxacum belorussicum Val. N. Tikhom seedlings explants. Plant Cell Tissue Organ. Cult. 2019, 139, 505–522. [Google Scholar] [CrossRef]
- Popielarska-Konieczna, M.; Kozieradzka-Kiszkurno, M.; Świerczyńska, J.; Góralski, G.; Ślesak, H.; Bohdanowicz, J. Are extracellular matrix surface network components involved in signalling and protective function? Plant Signal Behav. 2008, 3, 707–709. [Google Scholar] [CrossRef] [PubMed]
- Šamaj, J.; Bobák, M.; Blehová, A.; Pret’Ová, A. Importance of cytoskeleton and cell wall in somatic embryogenesis. Plant Cell Monogr. 2005, 2. [Google Scholar] [CrossRef]
- Šamaj, J.; Baluška, F.; Bobák, M.; Volkmann, D. Extracellular matrix surface network of embryogenic units of friable maize callus contains arabinogalactan-proteins recognized by monoclonal antibody JIM4. Plant Cell Rep. 1999, 18, 369–374. [Google Scholar] [CrossRef]
- Popielarska-Konieczna, M.; Sala, K.; Abdullah, M.; Tuleja, M.; Kurczyńska, E. Extracellular matrix and wall composition are diverse in the organogenic and non-organogenic calli of Actinidia arguta. Plant Cell Rep. 2020, 39, 779–798. [Google Scholar] [CrossRef]
- Zabicki, P.; Kuta, E.; Tuleja, M.; Rataj, K.; Malec, P. Arabidopsis cyclin-dependent kinase gene CDKG;2 is involved in organogenic responses induced in vitro. Acta Biol. Crac. Ser. Bot. 2013, 55, 37–48. [Google Scholar] [CrossRef]
- Wetmore, R.H.; Rier, J.P. Experimental Induction of Vascular Tissues in Callus of Angiosperms. Am. J. Bot 1963, 50, 418. [Google Scholar] [CrossRef]
- Jeffs, R.A.; Northcote, D.H. Experimental induction of vascular tissue in an undifferentiated plant callus. Biochem. J. 1966, 101, 146–152. [Google Scholar] [CrossRef]
- Ullrich, C.I.; Aloni, R. Vascularization is a general requirement for growth of plant and animal tumours. J. Exp. Bot. 2000, 51, 1951–1960. [Google Scholar] [CrossRef] [PubMed]
- Häsler, J.; Wüest, J.; Gaspar, T.; Crèvecoeur, M. Long term in vitro-cultured plant cells show typical neoplastic features at the cytological level. Biol. Cell 2003, 95, 357–364. [Google Scholar] [CrossRef] [PubMed]
- Ušák, D.; Haluška, S.; Pleskot, R. Callose synthesis at the center point of plant development—An evolutionary insight. Plant Physiol. 2023, 193, 54–69. [Google Scholar] [CrossRef]
- Björkman, O.; Demmig, B. Photon yield of O2 evolution and chlorophyll fluorescence characteristics at 77 K among vascular plants of diverse origins. Planta 1987, 170, 489–504. [Google Scholar] [CrossRef]
- Horton, P.; Ruban, A.V.; Walters, R.G. Regulation of light harvesting in green plants. Annu. Rev. Plant Physiol. Plant Mol. Biol. 1996, 47, 655–684. [Google Scholar] [CrossRef]
- Horton, P.; Ruban, A.V. Regulation of Photosystem II. Photosynth. Res. 1992, 34, 375–385. [Google Scholar] [CrossRef]
- Lichtenthaler, H.K.; Buschmann, C.; Knapp, M. How to correctly determine the different chlorophyll fluorescence parameters and the chlorophyll fluorescence decrease ratio RFd of leaves with the PAM fluorometer. Photosynthetica 2005, 43, 379–393. [Google Scholar] [CrossRef]
- M. Kȩdra; Bach, A. Morphogenesis of Lilium martagon L. explants in callus culture. Acta Biol. Crac. Ser. Bot. 2005, 47. [Google Scholar]
- Lowry, O.H.; Rosebrough, N.J.; Farr, A.L.; Randall, R.J. Protein measurement with the Folin phenol reagent. J. Biol. Chem. 1951, 193, 265–275. [Google Scholar] [CrossRef] [PubMed]
- Lichtenthaler, H.; Buschmann, C. Chlorophyll and Carotenoid Determination ( after Lichtenthaler 1987), a practical instruction. Methods Enzym. 1987, 8, 350–382. [Google Scholar]
- Giusti, M.M.; Wrolstad, R.E. Characterization and Measurement of Anthocyanins by UV-Visible Spectroscopy. Curr. Protoc. Food Anal. Chem. 2001, 1, F1–2. [Google Scholar] [CrossRef]
- Jensen, W.A. Botanical Histochemistry Principles and Practice; W.H. Freeman and Company: San Francisco and London, 1962. [Google Scholar]
- Tuleja, M.; Santocki, M.; Dziurka, M.; Musiał, K.; Capecka, E.; Libik-Konieczny, M. The search towards cyto-embryological and physiological obstacles in sexual reproduction of Stevia rebaudiana Bertoni. Sci. Hortic. 2021, 288, 110342. [Google Scholar] [CrossRef]
- Musiał, K.; Kościńska-Pająk, M.; Antolec, R.; Joachimiak, A.J. Deposition of callose in young ovules of two Taraxacum species varying in the mode of reproduction. Protoplasma 2015, 252, 135–144. [Google Scholar] [CrossRef] [PubMed]
- Kalaji, H.M.; Schansker, G.; Ladle, R.J.; Goltsev, V.; Bosa, K.; Allakhverdiev, S.I.; Brestic, M.; Bussotti, F.; Calatayud, A.; Dąbrowski, P.; et al. Frequently asked questions about in vivo chlorophyll fluorescence: Practical issues. Photosynth. Res. 2014, 122, 121–158. [Google Scholar] [CrossRef]
- Kalaji, H.M.; Schansker, G.; Brestic, M.; Bussotti, F.; Calatayud, A.; Ferroni, L.; Goltsev, V.; Guidi, L.; Jajoo, A.; Li, P.; et al. Frequently asked questions about chlorophyll fluorescence, the sequel. Photosynth. Res. 2016, 132, 13–66. [Google Scholar] [CrossRef]
Figure 2.
Schematic overview of the entire experiment, including illustrative examples of results. Leaf explants were taken from a T. farfara plant, which had already been regenerated from callus and grown in vitro (A), and then were used for the induction of callus (B). The pieces of callus, separated from the leaf explants, were passaged on solid medium and cultivated (C). In target tests, the callus pieces were transferred to suspension culture (D1) and on solid media (D2), with the addition of various hormones and grown in darkness. Finally, after 42 days of growth in darkness on solid and in suspension culture, the callus tissue was taken for biochemical analyses (D1, D2). Additionally, Petri dishes with the dark-grown callus, which developed regenerants were transferred to light conditions and further observed, with a focus on the organogenesis process (E, F).
Figure 2.
Schematic overview of the entire experiment, including illustrative examples of results. Leaf explants were taken from a T. farfara plant, which had already been regenerated from callus and grown in vitro (A), and then were used for the induction of callus (B). The pieces of callus, separated from the leaf explants, were passaged on solid medium and cultivated (C). In target tests, the callus pieces were transferred to suspension culture (D1) and on solid media (D2), with the addition of various hormones and grown in darkness. Finally, after 42 days of growth in darkness on solid and in suspension culture, the callus tissue was taken for biochemical analyses (D1, D2). Additionally, Petri dishes with the dark-grown callus, which developed regenerants were transferred to light conditions and further observed, with a focus on the organogenesis process (E, F).
Figure 3.
Induction and growth of callus under light conditions (75 μmol photons m-2 s -1; 14/10 (light/dark) photoperiod). A: Photos taken during callus induction (
Figure 2B). B: Photos taken during growth after callus initiation, following passage. t0 represents the day of callus passage, which is the starting point of observation; t14 and t28 represent observations performed after 14 and 28 days, respectively. The composition of the medium is specified in the figure.
Figure 3.
Induction and growth of callus under light conditions (75 μmol photons m-2 s -1; 14/10 (light/dark) photoperiod). A: Photos taken during callus induction (
Figure 2B). B: Photos taken during growth after callus initiation, following passage. t0 represents the day of callus passage, which is the starting point of observation; t14 and t28 represent observations performed after 14 and 28 days, respectively. The composition of the medium is specified in the figure.
Figure 4.
Induction and growth of callus under dark conditions. A: Photos taken during callus induction (
Figure 2B). B: Photos taken during growth after callus initiation, following passage; t0 represents the day of callus passage, which is the starting point of observation; t14 and t28 represent observations performed after 14 and 28 days, respectively. The composition of the medium is specified in the figure.
Figure 4.
Induction and growth of callus under dark conditions. A: Photos taken during callus induction (
Figure 2B). B: Photos taken during growth after callus initiation, following passage; t0 represents the day of callus passage, which is the starting point of observation; t14 and t28 represent observations performed after 14 and 28 days, respectively. The composition of the medium is specified in the figure.
Figure 5.
Callus growth characteristics. A: Growth kinetics (fresh weight), Growth Index (GI) and Relative Growth Rate (RGR; harvest interval: 7 days) of callus grown under dark condition on solid media (MS, 3 mg/l IAA; 2 mg/l BAP, 0,6% agar). B: Increase in fresh weight, Growth Index (GI) and Relative Growth Rate (RGR) for callus from solid and suspension cultures (MS, 3 mg/l IAA; 2 mg/l BAP) under dark conditions, measured on the 42nd day of culture. Average values and standard deviations are shown for n=25 callus fragments.
Figure 5.
Callus growth characteristics. A: Growth kinetics (fresh weight), Growth Index (GI) and Relative Growth Rate (RGR; harvest interval: 7 days) of callus grown under dark condition on solid media (MS, 3 mg/l IAA; 2 mg/l BAP, 0,6% agar). B: Increase in fresh weight, Growth Index (GI) and Relative Growth Rate (RGR) for callus from solid and suspension cultures (MS, 3 mg/l IAA; 2 mg/l BAP) under dark conditions, measured on the 42nd day of culture. Average values and standard deviations are shown for n=25 callus fragments.
Figure 6.
Results of biochemical tests performed on dark-grown 42-day-old solid and suspension cultures of T. farfara. A: Content of carotenoids, anthocyanins, and proteins. B: Content of chlorophylls and FV/FM; n=3, n represents individual pieces of callus.
Figure 6.
Results of biochemical tests performed on dark-grown 42-day-old solid and suspension cultures of T. farfara. A: Content of carotenoids, anthocyanins, and proteins. B: Content of chlorophylls and FV/FM; n=3, n represents individual pieces of callus.
Figure 8.
Organogenesis, color and structure of exemplary callus grown for 42 days on different media (as specified in the pictures). A: callus grown under light conditions 75 μmol photons m-2 s -1; 14/10 (light/dark) photoperiod; B: callus grown in dark conditions.
Figure 8.
Organogenesis, color and structure of exemplary callus grown for 42 days on different media (as specified in the pictures). A: callus grown under light conditions 75 μmol photons m-2 s -1; 14/10 (light/dark) photoperiod; B: callus grown in dark conditions.
Figure 9.
Histological analysis of callus sampling in 42 days after subculture A: (light-grown callus on MS) 2- Pass and Naphtol Blue Back staining, 3 – aniline blue staining; B: (light-grown callus on MS+3mg/L IAA+2mg/L BAP) 2- Pass and Naphtol Blue Back staining, 3 – aniline blue staining: C: (dark-grown callus on MS) 2- Pass and Naphtol Blue Back staining, 3 – aniline blue staining; D: (dark-grown calli on MS+3 mg/L IAA+2mg/L BAP) 2- Pass and Naphtol Blue Back staining, 3 – aniline blue staining. arrows – callose deposition, asterisk – regenerants, ecm – extra cellular matrix, mlc – meristematic like cells, uc - unfinished cytokinesis, mc - multinucleated cell, Scale bar of A1, B1, C1, D1, - 0,5 cm, light - 75 μmol photons m-2 s -1.
Figure 9.
Histological analysis of callus sampling in 42 days after subculture A: (light-grown callus on MS) 2- Pass and Naphtol Blue Back staining, 3 – aniline blue staining; B: (light-grown callus on MS+3mg/L IAA+2mg/L BAP) 2- Pass and Naphtol Blue Back staining, 3 – aniline blue staining: C: (dark-grown callus on MS) 2- Pass and Naphtol Blue Back staining, 3 – aniline blue staining; D: (dark-grown calli on MS+3 mg/L IAA+2mg/L BAP) 2- Pass and Naphtol Blue Back staining, 3 – aniline blue staining. arrows – callose deposition, asterisk – regenerants, ecm – extra cellular matrix, mlc – meristematic like cells, uc - unfinished cytokinesis, mc - multinucleated cell, Scale bar of A1, B1, C1, D1, - 0,5 cm, light - 75 μmol photons m-2 s -1.
Figure 10.
Photosynthetic activity of callus with regenerates. The culture was performed on MS, 3 mg/l IAA; 2 mg/l BAP under different photon flux densities (30, 70, and 90 μmol photons m-2 s-1). A: FV/FM measured during cultivation; the day of cultivation and light intensity is indicated in the figure; B: Coefficient of photochemical quenching (qP) and nonphotochemical quenching (NPQ) measured after 28 days (22 days after passage) of growth under various light intensities as shown in the legend; C: Vitality index (Rfd) measured in parallel to qP and NPQ values (see Material and Methods for explanation of fluorescence-derived parameters); A-C – Average values and standard deviations are shown for n=6; The yellow and gray rectangles indicate, respectively, the time of turning on and off the actinic light (600 μmol photons m-2 s-1). D: Fluorescence image of 28-day-old callus grown under different light intensities, as shown in figures.
Figure 10.
Photosynthetic activity of callus with regenerates. The culture was performed on MS, 3 mg/l IAA; 2 mg/l BAP under different photon flux densities (30, 70, and 90 μmol photons m-2 s-1). A: FV/FM measured during cultivation; the day of cultivation and light intensity is indicated in the figure; B: Coefficient of photochemical quenching (qP) and nonphotochemical quenching (NPQ) measured after 28 days (22 days after passage) of growth under various light intensities as shown in the legend; C: Vitality index (Rfd) measured in parallel to qP and NPQ values (see Material and Methods for explanation of fluorescence-derived parameters); A-C – Average values and standard deviations are shown for n=6; The yellow and gray rectangles indicate, respectively, the time of turning on and off the actinic light (600 μmol photons m-2 s-1). D: Fluorescence image of 28-day-old callus grown under different light intensities, as shown in figures.
Figure 11.
Sample images of callus cultured for 28 days on MS, 3 mg/l IAA; 2 mg/l BAP under light of different intensities, as shown in the figure, along with the corresponding chlorophyll fluorescence image.
Figure 11.
Sample images of callus cultured for 28 days on MS, 3 mg/l IAA; 2 mg/l BAP under light of different intensities, as shown in the figure, along with the corresponding chlorophyll fluorescence image.
Table 1.
Efficiency of callus induction on solid cultures with MS medium and different hormones under dark or light conditions (75 μmol photons m-2 s-1; 14/10 (light/dark) photoperiod). Plus signs (+, ++, +++) indicate the conventional scale of callus growth after initiation, while a minus sign (−) indicates no initiation. (IAA – indoleacetic; 2,4-D - 2,4-dichlorophenoxyacetic acid; NAA- naphthalene acetic acid; BAP - benzyl aminopurine.
Table 1.
Efficiency of callus induction on solid cultures with MS medium and different hormones under dark or light conditions (75 μmol photons m-2 s-1; 14/10 (light/dark) photoperiod). Plus signs (+, ++, +++) indicate the conventional scale of callus growth after initiation, while a minus sign (−) indicates no initiation. (IAA – indoleacetic; 2,4-D - 2,4-dichlorophenoxyacetic acid; NAA- naphthalene acetic acid; BAP - benzyl aminopurine.
Growth
conditions |
Hormone composition in MS medium |
Callus initiation
[+++ /-] |
| Light conditions |
2,4-D (1 mg/L) |
NAA (2 mg/L) |
BAP (2 mg/L) |
+ |
| 2,4-D (1.5 mg/L) |
NAA (2 mg/L) |
BAP (2 mg/L) |
+ |
| 2,4-D (2 mg/L) |
NAA (2 mg/L) |
BAP (2 mg/L) |
+ |
| IAA (3 mg/L) |
- |
BAP (2 mg/L) |
++ |
| |
| Dark conditions |
2,4-D (1 mg/L) |
NAA (2 mg/L) |
BAP (2 mg/L) |
+ |
| 2,4-D (2 mg/L) |
- |
BAP (3 mg/L) |
+/- |
| IAA (3 mg/L) |
- |
BAP (2 mg/L) |
+++ |
| IAA (2 mg/L) |
- |
BAP (2 mg/L) |
++ |
Table 2.
Photosynthetic pigment content in T. farfara leaves from plants grown in vitro and in callus from solid cultures grown under light and dark conditions. Light conditions were identical for both the callus and the plants: 70 μmol photons m-2 s -1 with a 14/10 (light/dark) photoperiod. Growth medium for plants: MS; growth medium for callus: MS with 3 mg/L IAA and 2 mg/L BAP. n=3, where n represents individual pieces of callus or leaves.
Table 2.
Photosynthetic pigment content in T. farfara leaves from plants grown in vitro and in callus from solid cultures grown under light and dark conditions. Light conditions were identical for both the callus and the plants: 70 μmol photons m-2 s -1 with a 14/10 (light/dark) photoperiod. Growth medium for plants: MS; growth medium for callus: MS with 3 mg/L IAA and 2 mg/L BAP. n=3, where n represents individual pieces of callus or leaves.
Growth condition
tissue |
Chl a
[ng/mg] |
Chl b [ng/mg] |
Carotenoids
[ng/mg] |
Chl a/
Chl b |
Chl/
carotenoids |
| Light conditions |
| leaves |
1095,3±148,6 |
345,5±45,0 |
244,3±32,1 |
3,17±0,04 |
5,90±0,22 |
| callus |
33,5±9,6 |
16,3±1,96 |
17,06±4,13 |
2,03±0,40 |
2,93±0,05 |
| Dark conditions (*) |
| callus |
0,78±0,56 |
1,48±0,88 |
3,51±0,58 |
0,50±0,08 |
0,66 ±0,40 |
Table 3.
Characteristics of callus and organogenesis in 42-day-old solid cultures; Growth condition and medium composition is specified in the table. Light conditions: 75 μmol photons m-2 s-1; 14/10 (light/dark) photoperiod. Regenerant types: root (R) leaf (L) shoots (S). The percentage of colored calli is given in brackets.
Table 3.
Characteristics of callus and organogenesis in 42-day-old solid cultures; Growth condition and medium composition is specified in the table. Light conditions: 75 μmol photons m-2 s-1; 14/10 (light/dark) photoperiod. Regenerant types: root (R) leaf (L) shoots (S). The percentage of colored calli is given in brackets.
| Growth condition |
Medium |
Callus color
and tint with another color [%] |
Calli with organogenesis |
White organs
[number] |
Green organs
[number] |
| |
|
|
[%] |
[number] |
R |
L |
S |
R |
L |
S |
| Light condition |
MS |
light brown tinted
on dark brown (10,9)
on violet (13) |
21,8 |
10 |
2 |
9 |
2 |
0 |
17 |
3 |
MS +
IAA (3 mg/L), BAP (2 mg/L) |
light brown tinted
on dark brown (26,1),
on yellow (26,1)
on violet (45) |
23,9 |
11 |
14 |
14 |
8 |
0 |
1 |
0 |
| Dark condition |
MS |
brown tinted
on yellow (13) |
19,4 |
9 |
11 |
4 |
3 |
0 |
0 |
0 |
MS +
IAA (3 mg/L), BAP (2 mg/L) |
light yellow tinted
on brown (15,2)
on violet (17,4) |
17,4 |
8 |
17 |
2 |
0 |
0 |
0 |
0 |
|
Disclaimer/Publisher’s Note: The statements, opinions and data contained in all publications are solely those of the individual author(s) and contributor(s) and not of MDPI and/or the editor(s). MDPI and/or the editor(s) disclaim responsibility for any injury to people or property resulting from any ideas, methods, instructions or products referred to in the content. |
© 2024 by the authors. Licensee MDPI, Basel, Switzerland. This article is an open access article distributed under the terms and conditions of the Creative Commons Attribution (CC BY) license (http://creativecommons.org/licenses/by/4.0/).